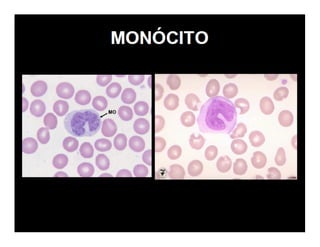

O documento descreve os principais órgãos e células do sistema imunológico, incluindo: (1) a diferenciação dos linfócitos T em subpopulações Th1, Th2 e Th17 que secretam citocinas diferentes; (2) a ativação dos linfócitos T CD8+ e B; (3) os principais órgãos linfóides como medula óssea, baço e linfonodos.